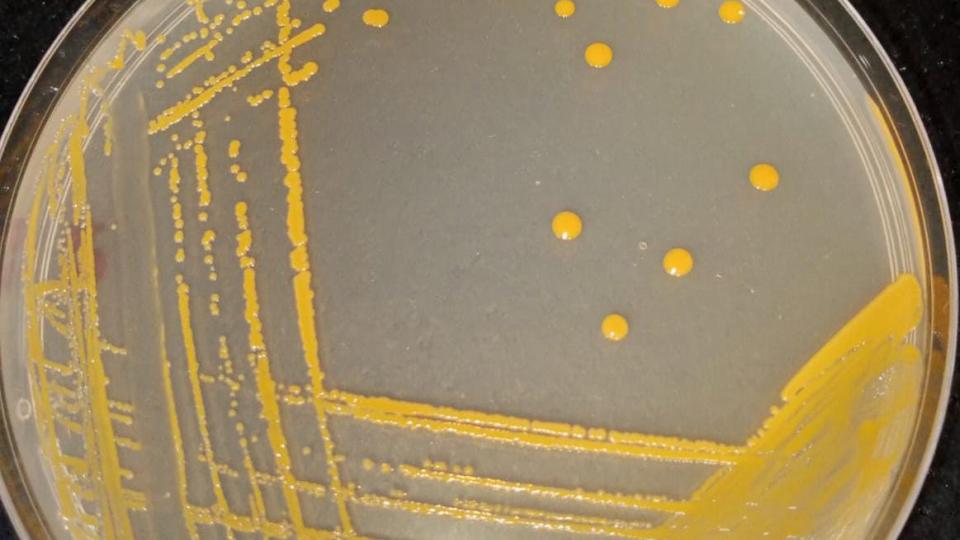
planococcus

Biodiversity, the foundation of biotechnology, is immense because the Earth has numerous unique ecosystems and niches, each with its own distinct set of challenges.
Lake Pastos Grandes in Bolivia is one such place: situated high up (4,440 m above sea level), it is chemically complex, with both hot and cold temperatures, and features alkaline and saline conditions. In extreme environments like this, thriving organisms are called extremophiles, and their adaptations to hostility are a source of technological ideas for the extremes that we want (or have to) endure, which are becoming increasingly common due to the environmental degradation we are exerting on the planet.
Jeanett Daga Quisbert set out to study a new species of the Planococcus sp., discovered by her research team in Lake Pastos Grandes. Her research, utilizing genomic and metabolomic techniques, is extending beyond the taxonomic identification of the bacterium to explore the biochemical strategies for its survival in this context, prospecting for molecules that can be applied to a wide range of uses, such as inert solutes, polymers, or surfactants.
Jeanett undertook this part of her research at Pontificia Universidad Católica del Perú (PUCP) under the supervision and guidance of Dr. Alfredo Ibañez. We also thank her local mentors in Bolivia, Dr. Jorge Quiyaguaman Leyton and Eng. Marco Arancibia Miranda from Universidad Mayor de San Simon for teaming up in this effort to bioprospect and valorize the increasingly fewer natural environments that remain free of direct human intervention.